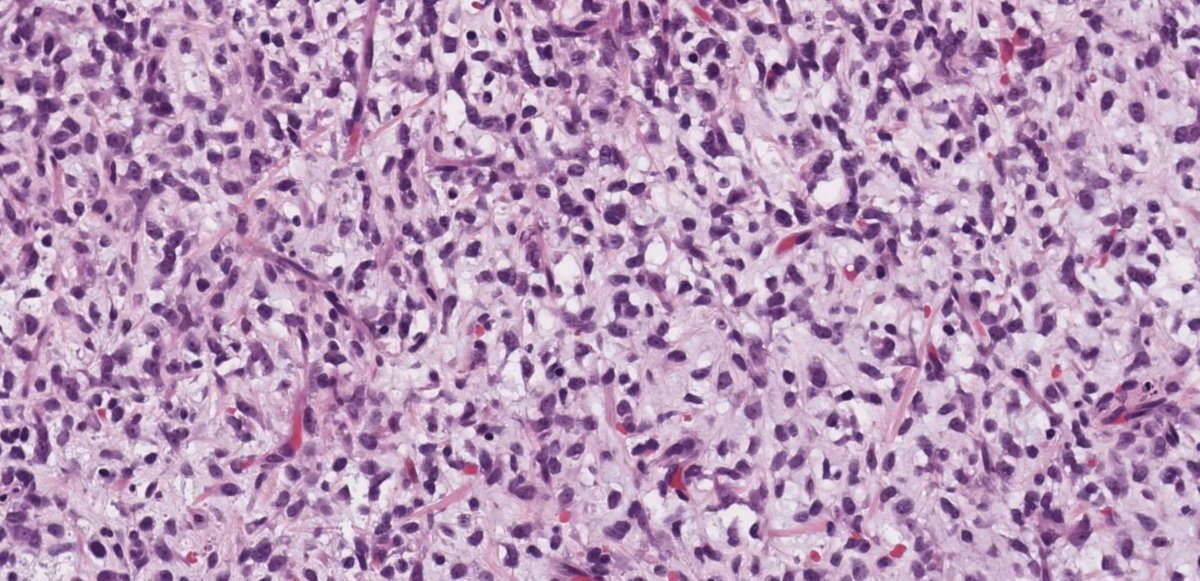
kiko4docs's tweet image. What is this myxoid tumor? 
Answer: kikoxp.com/posts/11195 
More posts from Dr. Hassell @HassellLewis kikoxp.com/lewis_a_hassel…
#pathology #pathTwitter #medTwitter #BSTpath

KiKo
@kiko4docs
KiKo is bringing doctors together on a new social platform. Tell your story and network with other doctors in your field.
You might like
What are these structures called in a nevus? What other tumor has similar structures? Answer (in comments): kikoxp.com/posts/15383 More posts from Dr. Moesch @moesch_john: kikoxp.com/john_moesch1 #medTwitter #pathology #pathTwitter #dermpath #dermatology #dermtwitter

Pancreatic mass in young adult male. EUS FNA. What is the diagnosis? What single stain could confirm it? Answers: kikoxp.com/posts/16463 More posts from Dr. Ingram @Chucktowndoc kikoxp.com/frank_ingram3 #pathology #pathTwitter #medTwitter



What would you call this lesion? WSI digital slide, Dermoscopy, & Answer (in comments): kikoxp.com/posts/5094 More posts from Dr. @VKazlouskaya kikoxp.com/viktoryia_kazl… #medTwitter #pathology #pathologists #pathTwitter #dermpath #dermatology #dermatologia #dermtwitter

For morphology lovers. Diagnosis? More pics & Answer: kikoxp.com/posts/9554 More posts from Dr. Cho @DrAldehyde kikoxp.com/woo_cheal_cho3 #medTwitter #pathology #pathologists #pathTwitter #dermpath #dermatology #dermatologia #dermtwitter

Posterior mediastinum of a woman. Diagnosis? More pics (with immunostains) & Answer: kikoxp.com/posts/8873 More posts from Dr. Cho @DrAldehyde kikoxp.com/woo_cheal_cho3 #pathology #pathTwitter #medTwitter

Young adult with lip lesion. Special stains negative. Diagnosis? Answer & More info: kikoxp.com/posts/9905 More posts from Dr. Rutland @TristanRutland7 kikoxp.com/tristan_rutlan… #pathology #pathTwitter #medTwitter #oralpath #ENTpath




Older adult patient, shin lesion. Diagnosis? Answer (in comments): kikoxp.com/posts/17586 More posts from Dr. Lozeau @LozeauMD kikoxp.com/daniel_lozeau1 #medTwitter #pathology #pathologists #pathTwitter #dermpath #dermatology #dermatologia #dermtwitter

63 M brain mass. Biopsy. Immunostain results & Diagnosis: kikoxp.com/posts/21837 More posts from Dr. Graham @DanGrahamMD kikoxp.com/daniel_graham #pathology #pathTwitter #medTwitter #neuropath #neurosurgery


What is this myxoid tumor? Answer: kikoxp.com/posts/11195 More posts from Dr. Hassell @HassellLewis kikoxp.com/lewis_a_hassel… #pathology #pathTwitter #medTwitter #BSTpath

What would you call this? Would you even comment? Answer: kikoxp.com/posts/9504 More posts from Dr. Hassell @HassellLewis kikoxp.com/lewis_a_hassel… #pathology #pathTwitter #medTwitter #gynpath

50 year old man with bloating, abdominal pain and some diarrhea. Diagnosis? Answer: kikoxp.com/posts/9355 More posts from Dr. Hassell @HassellLewis kikoxp.com/lewis_a_hassel… #pathology #pathTwitter #medTwitter #GIpath #IDpath

M59 y/o. polyp (5mm ) located 5cm from the anal margin. Adenoma or.....? More pics & Answer: kikoxp.com/posts/26411 More posts from Dr. Rey @ReyPathology kikoxp.com/severino_rey1 #pathology #pathTwitter #medTwitter #GIpath

What is that? Answer: kikoxp.com/posts/15048 More posts from Dr. Rey @ReyPathology kikoxp.com/severino_rey1 #pathology #pathTwitter #medTwitter




Skin lesion on the leg. F:49-year-old. What is your Dx? More pics & Answer: kikoxp.com/posts/15833 More posts from Dr. Rey @ReyPathology kikoxp.com/severino_rey1 #medTwitter #pathology #pathologists #pathTwitter #dermpath #dermatology #dermatologia #dermtwitter




What is your diagnosis? (hint: might be more than one!) WSI digital slide & Answer: kikoxp.com/posts/4590 More posts from Dr. @VKazlouskaya kikoxp.com/viktoryia_kazl… #medTwitter #pathology #pathologists #pathTwitter #dermpath #dermatology #dermtwitter

Tracheal mass, young adult. Diagnosis? More pics & Answer: kikoxp.com/posts/9678 More posts from Dr. Rutland @TristanRutland7 kikoxp.com/tristan_rutlan… #pathology #pathTwitter #medTwitter #pulmpath

Vulva mass. Diagnosis? More pics & Answer: kikoxp.com/posts/11514 More posts from Dr. Rutland @TristanRutland7 kikoxp.com/tristan_rutlan… #pathology #pathTwitter #medTwitter #gynpath #dermpath

Parotid gland, adult. What is your diagnosis? Answer: kikoxp.com/posts/11790 More posts from Dr. Rutland @TristanRutland7 kikoxp.com/tristan_rutlan… #pathology #pathTwitter #medTwitter #ENTpath



Chest lesion, older male. Diagnosis? Answer: kikoxp.com/posts/9341 More posts from Dr. Rutland @TristanRutland7 kikoxp.com/tristan_rutlan… #pathology #pathTwitter #medTwitter




Digit, adult. Diagnosis? (You will be shocked!) Answer: kikoxp.com/posts/7159 More posts from Dr. Rutland @TristanRutland7 kikoxp.com/tristan_rutlan… #pathology #pathTwitter #medTwitter #BSTpath




United States Trends
- 1. Colts 33.8K posts
- 2. Giants 78.7K posts
- 3. Chiefs 68.7K posts
- 4. Gibbs 14.4K posts
- 5. Jameis 38K posts
- 6. Lions 56.1K posts
- 7. Steelers 49.3K posts
- 8. JJ McCarthy 6,800 posts
- 9. Bears 64.6K posts
- 10. Mahomes 17.5K posts
- 11. Vikings 29.6K posts
- 12. #OnePride 4,789 posts
- 13. Ravens 26K posts
- 14. Shane Bowen 2,252 posts
- 15. Tomlin 6,746 posts
- 16. Tony Romo 3,484 posts
- 17. Bengals 21.9K posts
- 18. Daniel Jones 3,321 posts
- 19. Patriots 101K posts
- 20. Campbell 17.5K posts
You might like
-
 WC Faquin, MD, PhD
WC Faquin, MD, PhD
@bfaquin -
 Pembe Oltulu, MD
Pembe Oltulu, MD
@pembeoltulu -
 Fouad Boulos
Fouad Boulos
@fouad_boulos -
 Miruna Popescu, MD
Miruna Popescu, MD
@MirunaPopescu13 -
 Jason L. Hornick, M.D., Ph.D.
Jason L. Hornick, M.D., Ph.D.
@JLHornick -
 Gladell Paner, MD
Gladell Paner, MD
@GladellPaner -
 Shachar Path
Shachar Path
@Tiger_heme -
 Gary L. Keeney, M.D.
Gary L. Keeney, M.D.
@GaryKeeneyMD -
 Guoping Cai, MD
Guoping Cai, MD
@gcai1978 -
 Brian McMillen MD
Brian McMillen MD
@Teclis82 -
 Virtual Pathology Student Interest Group
Virtual Pathology Student Interest Group
@Path_SIG -
 Natasha Rekhtman MD PhD
Natasha Rekhtman MD PhD
@natasharekhtman -
 @Hemepathguy
@Hemepathguy
@hemepathguy -
 Monika Vyas
Monika Vyas
@Mvgs1706 -
 Dr. Bui Pathologist🌼
Dr. Bui Pathologist🌼
@DrBuiPathology
Something went wrong.
Something went wrong.












































































































































